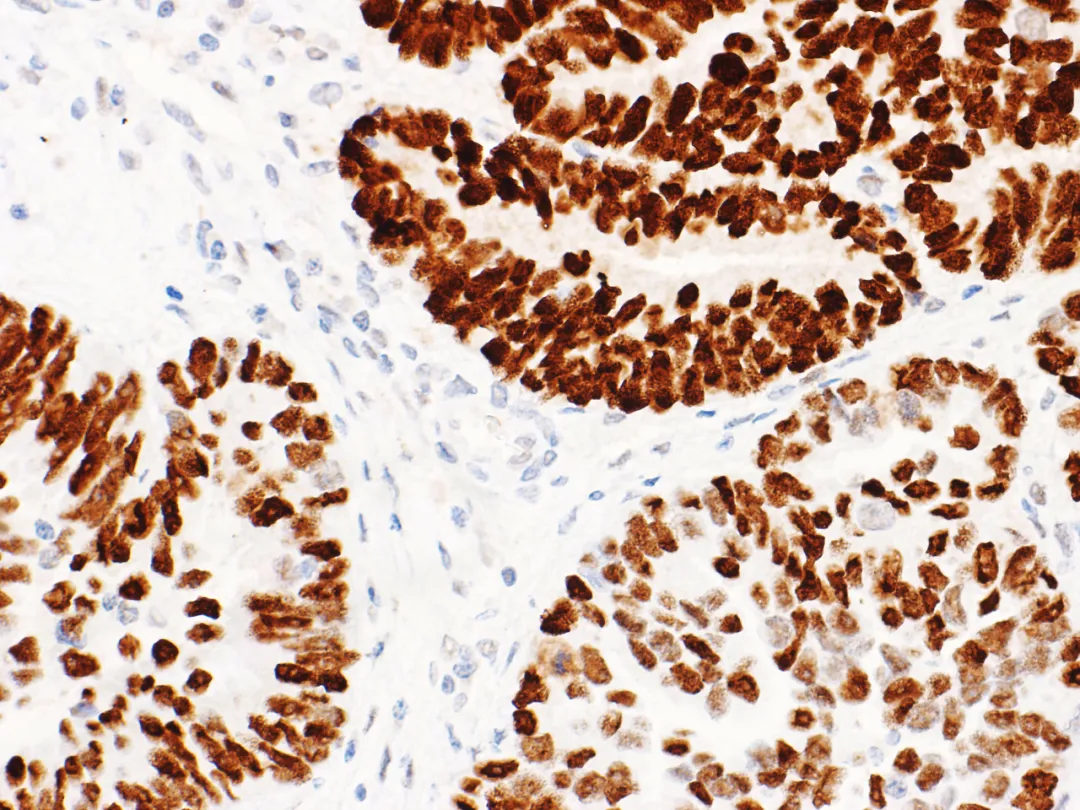
图片

Figure 1. High-grade ovarian serous carcinoma – Mutant p53 nuclear overexpression

Figure 2. Low-grade ovarian serous carcinoma – Wild-type p53 normal expression
Immunohistochemical p53 in low-grade serous carcinoma mostly expresses as wild-type. However, there are rare reports of a few cases with acquiredTp53gene mutation; such cases are extremely rare, so abnormal p53 staining patterns usually do not lead to a diagnosis of ovarian low-grade serous carcinoma. This is particularly important in the diagnosis of small biopsy cases, as some high-grade serous carcinomas may resemble low-grade serous carcinoma due to micropapillary structures and moderate nuclear atypia. It should be noted that about 2% of fallopian tube and ovarian high-grade serous carcinomas haveTp53gene mutations where the stop codon is beyond the normal position, resulting in non-functional p53 protein. Therefore, even serous tumors with normal p53 immunohistochemical expression may be ovarian high-grade serous carcinoma, so morphology should be combined and necessary molecular testing is recommended.
Multiple institutional studies have confirmed that abnormal p53 expression is associated with shortened survival time in ovarian endometrioid carcinoma. Similar results have been observed in stage I/IIA ovarian endometrioid carcinoma patients. In lower-stage ovarian endometrioid carcinoma, abnormal p53 expression is a reliable and strong prognostic indicator for survival.
The accuracy of immunohistochemical p53 results in predictingTp53gene mutation in ovarian mucinous tumors (as shown in Figure 3) is also relatively high. It indicates thatTp53gene mutation is associated with the progression of ovarian mucinous borderline tumors. Evaluating p53 status in a large number of ovarian mucinous tumors by immunohistochemistry did not find an association with prognosis. However, immunohistochemical p53 results in a small number of mucinous borderline tumors are associated with an increased risk of death. Although treatment options for such patients are limited, normal p53 immunohistochemical expression suggests a lower risk of progression in mucinous borderline tumors with unusual clinical manifestations (e.g., tumor rupture).

Figure 3. Ovarian seromucinous carcinoma – Wild-type p53 normal expression
Application of p53 Immunohistochemistry in Endometrial Cancer Diagnosis
p53 immunohistochemistry can predictTp53gene mutation in endometrial cancer (as shown in Figures 4 and 5).The heterogeneity of endometrial cancer makes interpretation difficult in approximately 5% of cases, and most of these cases are associated with POLE mutation or MMR deficiency.
The Cancer Genome Atlas (TCGA), based on whole-genome sequencing gene characteristics (presence or absence of POLE gene hypermutation, MMR deficiency, copy number abnormalities, etc.), proposed classifying endometrial cancer into 4 types: ① POLE hypermutated type, ② MSI-H type (microsatellite instability) or mismatch repair system deficient type, ③ MSS (microsatellite stable) or no specific molecular profile type or low copy number type, and ④ p53 mutated type or high copy number type.

Figure 4. Endometrial cancer – Wild-type p53 normal expression
Figure 5. Endometrial cancer – Mutant p53 nuclear overexpression
Tp53Gene mutation is characteristic of the high copy number type. Extensive somatic copy number abnormalities are features of endometrial serous carcinoma and endometrioid carcinoma described as ‘serous-like’. Studies have found that p53 mutated type endometrioid carcinoma grade 3 has a worse prognosis than endometrioid carcinoma grade 3 and may be sensitive to chemotherapy. High copy number type endometrial cancer withTp53gene mutation may correspond to Bokhman’s type II endometrial cancer, while low copy number type endometrial cancer corresponds to type I endometrial cancer.
Endometrial cancer patients with POLE mutation/mutant p53 or MMR deficiency/mutant p53 have better prognosis outcomes than those with onlyTp53gene mutation. p53 IHC currently has significant advantages over sequencing in detecting high copy number type and serous-like molecular subtypes of endometrial cancer.
Application of p53 Immunohistochemistry in Vulvar Squamous Cell Carcinoma Diagnosis
Vulvar squamous cell carcinoma has three molecular types: HPV-associated, HPV-independent/Tp53gene mutation, HPV-independent/Tp53gene normal. Accurate assessment of p53 status is crucial for classifying HPV-independent vulvar squamous cell carcinoma. Recent studies have shown that according to p53 immunohistochemistry interpretation criteria specifically for vulvar squamous cell carcinoma, its immunohistochemical results can accurately predictTp53gene mutation status in tumors.
Application of p53 Immunohistochemistry in Other Types of Gynecological Tumor Diagnosis
Uterine stromal tumors are found to have specific gene translocations or molecular alterations, such as high-grade endometrial stromal sarcoma with YWHAE-NUTM2A/B fusion, ZC3H7B-BCOR fusion, BCOR internal tandem duplication, inflammatory myofibroblastic tumor with ALK rearrangement, and spindle cell tumor with NTRK rearrangement. Although some immunohistochemistry can help narrow the differential diagnosis, such tumors generally require molecular testing for confirmation. Most leiomyosarcomas and undifferentiated pleomorphic sarcomas of the uterus haveTp53gene mutation. Therefore, the role of immunohistochemical p53 is to screen uterine stromal tumors without specific translocations but withTp53gene mutation for further molecular testing.
References
1.M Köbel, Piskorz AM, Lee S, et al. Optimized p53 immunohistochemistry is an accurate predictor of TP53 mutation in ovarian carcinoma[J]. Journal of Pathology Clinical Research, 2016, 2(4):247-258.
2.Köbel M, Kang EY. The Many Uses of p53 Immunohistochemistry in Gynecological Pathology: Proceedings of the ISGyP Companion Society Session at the 2020 USCAP Annual9 Meeting. Int J Gynecol Pathol. 2021;40(1):32-40.
3.Singh N, Piskorz A M, Bosse T, et al. p53 immunohistochemistry is an accurate surrogate for TP53 mutational analysis in endometrial carcinoma biopsies[J]. The Journal of Pathology, 2020, 250.